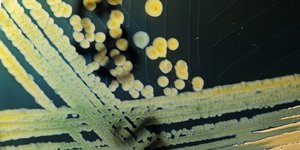

ΤΟΞΙΚΟ
OΛΕΣ ΟΙ ΕΙΔΗΣΕΙΣ ΚΑΙ ΤΑ ΤΕΛΕΥΤΑΙΑ ΝΕΑ ΓΙΑ ΤΟ TAG ΤΟΞΙΚΟ

ΕΛΛΑΔΑ 16/03/2012 15:35
Εισαγγελική έρευνα για τον υδράργυρο στο Μετρό Θεσσαλονίκης

ΥΓΕΙΑ 23/06/2011 12:26
Δεν αντιμετωπίζεται με συνηθισμένα αντιβιoτικά το E.coli
